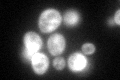
YJR014W
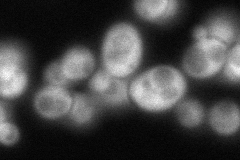
YJR014W

View description
Protein of unknown function; associates with ribosomes and has a putative RNA binding domain; interacts with Tma20p; similar to human GRAP and human DRP1, which interacts with human Tma20p homolog MCT-1
Localization:
Intensity:
Fold change:
Significance:
-
C’ GFP library in SD
cytosol91.57 -
N' NOP1pr-GFP in SD

cytosol242.962 -
N' TEF2pr-mCherry in SD

vacuole0 -
N' NATIVEpr-GFP in SD
cytosol90.799 -
N' TEF2pr-VC and Cyto-VN in SD

cytosol72.2011 -
C’ GFP library in SD+DTT

cytosol79.410.86No -
C’ GFP library in SD+H2O2

cytosol82.480.9No -
C’ GFP library in Starvation Media

cytosol67.180.73No -
C’ GFP library on the background of Pup2-DaMP

cytosol -
C’ GFP library on the background of CCT mutant

cytosol79.99340.873468No
